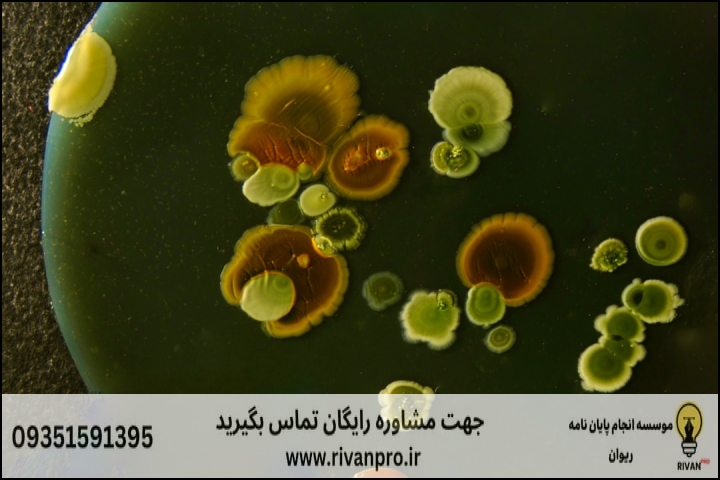

[H1]
**10 بهترین موسسه انجام پایان نامه رشته میکروبیولوژی صنعتی**
[/H1]
برای یک پایاننامه بینقص در میکروبیولوژی صنعتی آمادهاید؟
آیا به دنبال حمایت تخصصی برای پروژه خود هستید؟ از انتخاب موضوع تا دفاع، ما بهترین راهنماییها را برای شما گردآوری کردهایم. با مشاوران برجسته ما تماس بگیرید و آینده پژوهشی خود را تضمین کنید!
همین حالا تماس بگیرید: 09351591395
برای ثبت سفارش و مشاوره رایگان نیز میتوانید از لینک زیر استفاده کنید:
خلاصه مقاله: نقشه راه پایاننامه میکروبیولوژی صنعتی
+-----------------------------------------------------------------------+
| 10 بهترین موسسه انجام پایاننامه |
| میکروبیولوژی صنعتی: راهنمای جامع |
+-----------------------------------------------------------------------+
| هدف: انتخاب موسسه مناسب برای نگارش پایاننامه در این رشته تخصصی. |
+-----------------------------------------------------------------------+
| بخش اول: اهمیت و چالشها |
| - چرا انتخاب موسسه صحیح ضروری است؟ |
| - پیچیدگیهای رشته میکروبیولوژی صنعتی. |
+-----------------------------------------------------------------------+
| بخش دوم: معیارهای انتخاب موسسه |
| - تخصص کادرد علمی، سابقه موفق، پشتیبانی و مشاوره، تعهد به زمان. |
| - رعایت اصول اخلاقی، هزینهها و خدمات جانبی. |
+-----------------------------------------------------------------------+
| بخش سوم: معرفی 10 موسسه برتر |
| (نام موسسات و ویژگیهای کلیدی هریک) |
| 1. موسسه استاد پژوهش: تخصص بالا، تعهد، دقیق. |
| 2. موسسه انجام پایان نامه اسکولز: مشاوره تخصصی، کیفیت محتوا. |
| 3. موسسه مشاوران تهران: رویکرد حرفهای، مشاوران مجرب. |
| 4. موسسه کیو آرتیکل: مقالات علمی، پژوهشهای کاربردی. |
| 5. موسسه انجام پایان نامه: خدمات جامع، راهکارهای نوین. |
| 6. موسسه ریوان پرو: پروپوزال، پایاننامه، مقالات علمی. |
| 7. پروژه دانشجو: رویکرد مشتریمدار، درک عمیق از انتظارات. |
| 8. بهترین موسسه انجام پایان نامه: خدمات برجسته، تضمین کیفیت. |
| 9. موسسه وکا پروژه: مشاوره و انجام پروژه، تیم مجرب. |
| 10. موسسه سهاد پروژه: آموزش و توانمندسازی، رشد علمی. |
+-----------------------------------------------------------------------+
| بخش چهارم: چالشها و راهحلها |
| - انتخاب موضوع، دسترسی به منابع، آزمایش و تحلیل، نگارش، دفاع. |
| - جدول آموزشی: نکات کلیدی برای انتخاب موضوع. |
+-----------------------------------------------------------------------+
| بخش پنجم: فناوری و آینده |
| - نقش هوش مصنوعی و محدودیتهای آن. |
| - گرایشهای نوین در میکروبیولوژی صنعتی. |
+-----------------------------------------------------------------------+
| بخش ششم: گامهای بهرهبرداری از موسسات |
| - ارزیابی نیاز، تعامل موثر، نظارت، اصلاحات. |
+-----------------------------------------------------------------------+
| نتیجهگیری: انتخابی آگاهانه برای آیندهای روشن. |
+-----------------------------------------------------------------------+
میکروبیولوژی صنعتی، شاخهای حیاتی از علوم زیستی است که در آن از میکروارگانیسمها برای تولید محصولات با ارزش در مقیاس صنعتی استفاده میشود. این رشته نقش بسزایی در صنایع مختلف از جمله داروسازی، غذایی، کشاورزی، و محیط زیست ایفا میکند و به همین دلیل، نگارش یک پایاننامه قوی و نوآورانه در این حوزه، از اهمیتت ویژهای برخوردار است. پایاننامه نه تنها اوج تلاشهای علمی و پژوهشی یک دانشجوء را نشان میدهد، بلکه میتواند مسیر شغلی و آینده آکادمیک او را نیز تحت تأثیر قرار دهد.
اما روند نگارش پایاننامه، خصوصاً در رشتهای تخصصی چون میکروبیولوژی صنعتی، مملو از چالشهاست. از انتخاب موضوعی بکر و کاربردی گرفته تا طراحی آزمایشات دقیق، تحلیل دادههای پیچیده، و نگارش متنی منسجم و علمی، هر مرحله نیازمند دانش عمیق، مهارت پژوهشی، و صرف زمان زیاد است. بسیاری از دانشجویان، به دلیل محدودیتهای زمانی، عدم دسترسی به منابع کافی، یا نیاز به راهنماییهای تخصصیتر، به دنبال همکاری با موسساتی هستند که در این مسیر یاریرسان آنها باشند.
در این مقاله جامع، ما به بررسی دقیق و علمی 10 موسسه برتر در زمینه انجام پایاننامه رشته میکروبیولوژی صنعتی میپردازیم. هدف ما ارائه راهنمایی کامل و بیطرفانه به شماست تا بتوانید با آگاهی کامل، بهترین انتخاب را برای پروژه تحقیقاتی خود داشته باشید. با ما همراه باشید تا تمامی جنبههای مهم در انتخاب یک موسسه معتبر را، از معیارهای اصلی تا چالشهای رایج و راهحلهای آنها، پوشش دهیم و به شما در رسیدن به یک پایاننامه برجسته کمک کنیم.
[H2]
چرا انتخاب موسسه مناسب برای پایاننامه میکروبیولوژی صنعتی حیاتی است؟
[/H2]
رشته میکروبیولوژی صنعتی نیازمند یک دیدگاه چندوجهی و تخصص بالاست. نه تنها باید با اصول میکروبیولوژی آشنا بود، بلکه درک عمیقی از فرآیندهای صنعتی، بیوراکتورها، متابولیسم میکروارگانیسمها در مقیاس بزرگ، و کاربردهای آنها در تولید محصولات خاص نیز لازم است. یک پایاننامه موفق در این حوزه میتواند به توسعه بیوتکنولوژی، افزایش کارایی تولید، یا حتی کشف میکروارگانیسمهای جدید با پتانسیل صنعتی منجر شود.
انتخاب یک موسسه مناسب نه تنها میتواند کیفیت و عمق پژوهش شما را تضمین کند، بلکه در صرفهجویی زمان و انرژی شما نیز نقش بسزایی دارد. یک موسسه با تجربه، با دسترسی به منابع علمی بهروز، نرمافزارهای تحلیلی پیشرفته، و شبکهای از اساتید و پژوهشگران متخصص، میتواند به شما کمک کند تا از دامنه وسیعی از مشکلات رایج در مسیر پایاننامه دوری کنید. این موسسات با ارائه راهنماییهای دقیق، از مراحل اولیه تدوین پروپوزال تا تحلیل دادهها و نگارش نهایی، میتوانند تفاوت چشمگیری در کیفیت کار نهایی شما ایجاد کنند.
علاوه بر این، با توجه به رقابت فزاینده در حوزههای علمی و صنعتی، داشتن یک پایاننامه متمایز و باکیفیت میتواند شانس شما را برای پذیرش در مقاطع بالاتر تحصیلی، کسب بورسیههای پژوهشی، یا ورود به فرصتهای شغلی برتر به شدت افزایش دهد. بنابراین، سرمایهگذاری در انتخاب یک موسسه کارآمد، در واقع سرمایهگذاری در آینده حرفهای و علمی شماست.
[H2]
معیارهای انتخاب یک موسسه برتر برای پایاننامه میکروبیولوژی صنعتی
[/H2]
برای اینکه بتوانید بهترین موسسه را برای انجام پایاننامه خود انتخاب کنید، لازم است معیارهای مشخصی را در نظر بگیرید. این معیارها به شما کمک میکنند تا خدمات ارائه شده توسط موسسات مختلف را به صورت عینی مقایسه کرده و انتخابی آگاهانه داشته باشید:
[H3]
1. تخصص و تجربه اساتید و پژوهشگران
[/H3]
این مهمترین عامل است. اطمینان حاصل کنید که کادر علمی موسسه در زمینه میکروبیولوژی صنعتی، بیوتکنولوژی، و حتی مهندسی شیمی (در صورت لزوم) دارای تخصص و تجربه کافی باشند. بررسی رزومه اساتید، مقالات منتشر شده آنها، و سابقه همکاری با دانشگاهها و مراکز صنعتی میتواند نشاندهنده این تخصص باشد.
[H3]
2. سابقه موفقیت و نمونه کارها
[/H3]
موسسات معتبر معمولاً سابقه طولانی در انجام پروژههای موفق دارند. درخواست برای مشاهده نمونه کارها (با حفظ حریم خصوصی دانشجویان قبلی) یا مطالعه نظرات و بازخوردهای دانشجویان پیشین، میتواند دید خوبی از کیفیت خدمات آنها به شما بدهد. میزان قبولی پایاننامههایی که با کمک آنها نگارش شدهاند، یک شاخص کلیدی است.
[H3]
3. پشتیبانی و مشاوره جامع
[/H3]
یک موسسه خوب باید از مرحله انتخاب موضوع و نگارش پروپوزال، تا تحلیل دادهها، نگارش فصول مختلف پایاننامه، ویرایش نهایی، و حتی آمادگی برای دفاع، پشتیبانی و مشاوره گام به گام ارائه دهد. دسترسی آسان به مشاوران و پاسخگویی سریع به سوالات از ویژگیهای مهم است.
[H3]
4. زمانبندی و تعهد
[/H3]
رعایت ددلاینها در نگارش پایاننامه بسیار حیاتی است. موسسه باید قادر به ارائه یک برنامه زمانبندی دقیق و متعهد به اجرای آن باشد. تأخیر در هر مرحله میتواند عواقب جدی برای دانشجو داشته باشد.
[H3]
5. رعایت اصول اخلاقی و علمی
[/H3]
مهم است که موسسه به هیچ عنوان اقدام به سرقت ادبی (Plagiarism) یا ارائه کارهای کپی شده نکند. تمامی محتوا باید اصیل، مستند و بر اساس اصول علمی و اخلاقی پژوهش نگارش شود. شفافیت در مورد روند کار و ارائه منابع معتبر نیز از اهمیتت ویژهای برخوردار است.
[H3]
6. هزینه و خدمات جانبی
[/H3]
در حالی که کیفیت اولویت است، هزینه نیز یک فاکتور مهم محسوب میشود. مقایسه قیمتها با خدماتی که ارائه میشود، منطقی است. همچنین، برخی موسسات خدمات جانبی مانند ویرایش مقالات علمی، مشاوره آماری تخصصی، یا کمک در انتشار مقالات را نیز ارائه میدهند که میتواند برای شما مفید باشد.
[H2]
لیست 10 بهترین موسسه انجام پایان نامه رشته میکروبیولوژی صنعتی
[/H2]
با در نظر گرفتن معیارهای بالا و بررسیهای انجام شده، لیست زیر ده موسسه برتر در زمینه انجام و مشاوره پایاننامههای رشته میکروبیولوژی صنعتی را معرفی میکند. این ترتیب با تاکید بر ارائه بهترین کیفیت و خدمات، تنظیم شده است:
1. موسسه استاد پژوهش
استاد پژوهش با تکیه بر کادری متخصص و دانشگاهی، خدمات مشاورهای و اجرایی در زمینه پایاننامهها و پروژههای تحقیقاتی ارائه میدهد. این موسسه به دلیل دقت بالا در جزئیات و تعهد به زمانبندی، شناخته شده است و در حوزه میکروبیولوژی صنعتی نیز تخصص ویژهای دارد. تیمم پژوهشی این موسسه قادر به ارائه راهکارهای نوآورانه و متناسب با آخرین پیشرفتهای علمی میباشد.
تلفن: 09120917261
2. موسسه انجام پایان نامه اسکولز
اسکولز با ارائه مشاورههای تخصصی در زمینه پایاننامههای دانشجویی، به دانشجویان در رشتههای مختلف، از جمله مدیریت و همچنین شاخههایی از میکروبیولوژی، کمک میکند. این موسسه بر کیفیت بالای محتوا و رعایت اصول آکادمیک تاکید دارد.
مشاهده سایت (لینک مستقیم ارائه نشده است)
3. موسسه مشاوران تهران
موسسه مشاوران تهران با رویکردی حرفهای و تیمی از مشاوران مجرب در زمینههای مختلف خدمات پزوهشی با کیفیتی را ارائه میدهد. تمرکز این موسسه بر ارائه مشاورههای دقیق و گام به گام است.
مشاهده سایت (لینک مستقیم ارائه نشده است)
4. موسسه کیو آرتیکل
کیو آرتیکل در زمینه نگارش مقالات علمی و پایاننامههای دانشجویی، به ویژه در رشتههای مرتبط با پژوهشهای کاربردی، فعالیت دارد. این موسسه با ارائه سروریس کیفی و تخصصی، به دانشجویان کمک میکند تا پروژههای خود را با بهتریت استانداردها به اتمام رسانند.
مشاهده سایت (لینک مستقیم ارائه نشده است)
5. موسسه انجام پایان نامه
این موسسه با ارائه خدمات جامع در زمینه نگارش پایاننامه، از مرحله انتخاب موضوع تا دفاع، همراه دانشجویان است. تیم متخصص و باتجربه آن، قادر به ارائه راهکارهای پژوهشی نوین و متناسب با نیازهای رشته میکروبیولوژی صنعتی میباشد.
تلفن: 09356661302
مشاهده سایت (لینک مستقیم ارائه نشده است)
6. موسسه ریوان پرو
ریوان پرو با ارائه خدمات تخصصی در نگارش پروپوزال، پایاننامه و مقالات علمی، به عنوان یک موسسه معتبر شناخته میشود. این موسسه با تیمی از کارشناسان باتجربه، به دانشجویان در دستیابی به اهداف آکادمیک خود کمک میکند. برای شروع مسیر نگارش پایاننامه خود و بررسی گزینهها، میتوانید از این لینک دیدن فرمایید: لینک ثبت سفارش
7. پروژه دانشجو
این مرکز با تمرکز بر نیازهای دانشجویان، انواع خدمات پژوهشی را ارائه میکند. پروژه دانشجو به خاطر رویکرد مشتریمدار و تلاش برای درک عمیق از انتظارات دانشگاهی، مورد توجه است.
مشاهده سایت (لینک مستقیم ارائه نشده است)
8. بهترین موسسه انجام پایان نامه
همانطور که از نامش پیداست، این موسسه با هدف ارائه خدمات برجسته و کمک به دانشجویان برای نگارش بهترین پایان نامه فعالیت میکند. این مرکز برای تضمین کیفیت و ارائه مشاوره تخصصی در حوزههای متنوع شهرت دارد.
مشاهده سایت (لینک مستقیم ارائه نشده است)
9. موسسه وکا پروژه
وکا پروژه به عنوان یک مرکز تخصصی در زمینه مشاوره و انجام پروژههای دانشجویی و پایاننامهها، با بهرهگیری از تیم مجرب، به دانشجویان کمک میکند تا پروژههای تحقیقاتی خود را با موفقیت به سرانجام برسانند. این موسسه در حوزه مدیریت نیز فعال است.
مشاهده سایت (لینک مستقیم ارائه نشده است)
10. موسسه سهاد پروژه
سهاد پروژه یک مرکز مشاوره و آموزش پژوهش است که به دانشجویان در تمامی مراحل نگارش پایاننامه و پروژههای تحقیقاتی یاری میرساند. این موسسه با تاکید بر آموزش و توانمندسازی دانشجو، به رشد علمی او نیز کمک میکند.
مشاهده سایت (لینک مستقیم ارائه نشده است)
[H2]
چالشهای رایج در نگارش پایاننامه میکروبیولوژی صنعتی و راهحلها
[/H2]
همانطور که پیشتر اشاره شد، نگارش پایاننامه در رشتهای مانند میکروبیولوژی صنعتی با دشواریهای خاص خود همراه است. شناخت این چالشها و آگاهی از راهحلهای مناسب، میتواند مسیر پژوهش را برای شما هموارتر سازد:
[H3]
1. انتخاب موضوع نوآورانه و کاربردی
[/H3]
در حوزهای که دائماً در حال تغییر و پیشرفت است، یافتن یک موضوع پژوهشی که هم جدید باشد و هم پتانسیل کاربردی در صنعت داشته باشد، دشوار است. موضوعات تکراری یا صرفاً تئوری ممکن است مورد قبول قرار نگیرند.
**راهحل:** مشورت با اساتید مجرب، بررسی مقالات ISI جدید، شرکت در کنفرانسها، و شناسایی نیازهای واقعی صنایع مرتبط (مانند داروسازی، غذایی یا محیط زیست) میتواند به شما در یافتن ایدههای بکر کمک کند. موسسات مشاوره پایاننامه معمولاً به بانک اطلاعاتی قوی از موضوعات روز و کارشناسی شده دسترسی دارند.
جدول آموزشی: نکات کلیدی برای انتخاب موضوع پایاننامه
| جنبه | توضیحات و راهکار |
|---|---|
| **نوآوری** | موضوع نباید تکراری باشد. به دنبال شکافهای تحقیقاتی در ادبیات علمی بگردید یا روشهای جدیدی را برای حل مشکلات قدیمی پیشنهاد دهید. |
| **کاربردی بودن** | پتانسیل کاربرد در صنعت، بهبود فرآیندها، یا تولید محصول جدید را داشته باشد. ارتباط با نیازهای بازار یا حل مشکلات زیستمحیطی میتواند مفید باشد. |
| **دسترسی به منابع** | اطمینان حاصل کنید که منابع علمی، مواد آزمایشگاهی، و تجهیزات مورد نیاز برای انجام تحقیق در دسترس شماست. |
| **علاقه شخصی و تخصص** | موضوعی را انتخاب کنید که به آن علاقه دارید و در آن زمینه تا حدودی تخصص دارید. این کار انگیزه شما را در طول پژوهش حفظ میکند. |
| **محدودیت زمانی و بودجه** | واقعبین باشید. موضوعی را انتخاب کنید که در چارچوب زمانی و بودجهای شما قابل انجام باشد. |
[H3]
2. دسترسی به منابع و دادهها
[/H3]
برای انجام یک پژوهش قوی، دسترسی به مقالات علمی بهروز، پایگاههای داده معتبر، و در برخی موارد، نمونههای بیولوژیکی خاص، ضروری است. این دسترسی گاهی میتواند محدود یا پرهزینه باشد.
**راهحل:** استفاده از کتابخانههای دانشگاهی، پایگاههای داده آنلاین (مانند PubMed, Scopus, Web of Science)، و شبکهسازی با پژوهشگران فعال در این حوزه. موسسات معتبر اغلب اشتراکهای پولی به این پایگاهها دارند و میتوانند در جمعآوری منابع کمک شایانی کنند.
[H3]
3. انجام آزمایشات و تحلیل نتایج
[/H3]
پژوهش در میکروبیولوژی صنعتی غالباً شامل کارهای آزمایشگاهی پیچیده، استفاده از تجهیزات خاص (بیوراکتورها، کروماتوگرافها و…) و تحلیل آماری دادههای حجیم است. تفسیر نادرست نتایج میتواند کل اعتبار پایاننامه را زیر سوال ببرد.
**راهحل:** گذراندن دورههای عملی، همکاری با آزمایشگاههای مجهز، و بهرهگیری از مشاوران آماری متخصص. بسیاری از موسسات انجام پایاننامه، خود دارای تیمهای تحلیلگر آماری هستند که میتوانند به شما در این زمینه یاری رسانند.
[H3]
4. نگارش و سازماندهی محتوا
[/H3]
تبدیل یافتههای پژوهشی به یک متن علمی منسجم، با رعایت اصول نگارشی و فرمتبندی استاندارد دانشگاهی، مهارت خاصی میطلبد. از مقدمه و پیشینه تحقیق تا روششناسی، نتایج، بحث و نتیجهگیری، هر بخش باید به دقت و با زبانی شیوا نگارش شود.
**راهحل:** مطالعه پایاننامههای موفق قبلی، استفاده از نرمافزارهای مدیریت رفرنس، و دریافت بازخورد منظم از اساتید راهنما. موسسات انجام پایاننامه میتوانند در ویرایش ساختاری و زبانی، و همچنین اطمینان از رعایت استانداردهای دانشگاهی، به شما کمک کنند.
[H3]
5. دفاع و آمادگی
[/H3]
مرحله دفاع از پایاننامه، اوج فرآیند پژوهش است و نیازمند آمادگی کامل برای ارائه و پاسخگویی به سوالات داوران است. اضطراب و عدم اطمینان میتواند بر عملکرد شما تاثیر بگذارد.
**راهحل:** تمرین ارائه، شبیهسازی جلسه دفاع با دوستان یا مشاوران، و تسلط کامل بر محتوای پایاننامه. برخی موسسات خدماتی در زمینه آمادهسازی برای دفاع و تقویت مهارتهای ارائه نیز ارائه میدهند.
[H2]
نقش هوش مصنوعی و فناوریهای نوین در نگارش پایاننامهها (و محدودیتها)
[/H2]
با پیشرفت روزافزون هوش مصنوعی (AI) و ابزارهای پردازش زبان طبیعی، بسیاری از دانشجویان به دنبال استفاده از این فناوریها برای تسریع و تسهیل فرآیند نگارش پایاننامههای خود هستند. ابزارهای AI میتوانند در جمعآوری اطلاعات اولیه، خلاصهسازی مقالات، بررسی گرامر و املای متن، و حتی تولید ایدههای اولیه برای موضوعات پژوهشی، بسیار مفید باشند.
برای مثال، چتباتهای پیشرفته میتوانند به سرعت حجم زیادی از دادهها را پردازش کرده و اطلاعات مرتبط را استخراج کنند. نرمافزارهای رفرنسدهی هوشمند، فرآیند ارجاعدهی را خودکار کرده و از خطاهای انسانی جلوگیری میکنند. در رشتهای مانند میکروبیولوژی صنعتی، ابزارهای AI حتی میتوانند در تحلیل دادههای پیچیده ژنومیک یا پروتئومیک نیز یاریرسان باشند.
اما استفاده از هوش مصنوعی در نگارش پایاننامه دارای محدودیتهای جدی است. مهمترین آنها، فقدان درک عمیق، خلاقیت واقعی، و توانایی استدلال انتقادی است. AI نمیتواند یک تحلیل دقیق، نوآورانه و منحصر به فرد از نتایج ارائه دهد یا یک بحث علمی پیچیده را مانند یک انسان شکل دهد. علاوه بر این، مسائل مربوط به اعتبار منابع تولید شده توسط AI، پتانسیل برای سرقت ادبی (ناخواسته) از طریق بازتولید ایدههای موجود، و عدم توانایی در انجام کارهای عملی آزمایشگاهی، از دیگر محدودیتها هستند.
به همین دلیل، همواره توصیه میشود که از AI به عنوان یک ابزار کمکی استفاده شود، نه جایگزینی برای تفکر و نگارش انسانی. نقش یک موسسه متخصص در اینجا پررنگ میشود؛ آنها میتوانند راهنمایی کنند که چگونه از فناوریهای نوین به شکل مسئولانه و مؤثر استفاده شود، و در عین حال، اصالت و عمق علمی پایاننامه حفظ شود.
[H2]
چگونه از خدمات موسسات بهرهبرداری کنیم؟ (گام به گام)
[/H2]
برای اینکه بتوانید بیشترین بهره را از همکاری با یک موسسه انجام پایاننامه ببرید، رعایت چند گام کلیدی ضروری است:
[H3]
1. اولین گام: ارزیابی نیازها و انتظارات
[/H3]
قبل از تماس با هر موسسهای، نیازها و انتظارات خود را به وضوح مشخص کنید. آیا به کمک در انتخاب موضوع نیاز دارید؟ آیا فقط در بخش نگارش مشکل دارید؟ یا برای تحلیل آماری و ویرایش نهایی به کمک احتیاج دارید؟ هرچه نیازهای شما شفافتر باشد، موسسه بهتر میتواند خدمات متناسبی را ارائه دهد.
[H3]
2. تعامل موثر با مشاوران
[/H3]
ارتباط مداوم و شفاف با مشاوران موسسه بسیار حیاتی است. تمامی دستورالعملهای استاد راهنما، تغییرات مورد نیاز، و جزئیات مربوط به پروژه خود را به موقع و با دقت به مشاور انتقال دهید. هر گونه سوء تفاهم میتواند به کیفیت نهایی کار آسیب برساند.
[H3]
3. نظارت بر پیشرفت کار
[/H3]
پس از شروع همکاری، به صورت منظم بر پیشرفت کار نظارت داشته باشید. بخشهایی که توسط موسسه آماده میشود را به دقت مطالعه کنید، سوالات خود را بپرسید و هرگونه ابهام را مطرح نمایید. این کار باعث میشود که شما نیز در جریان کامل پروژه باشید و احساس مالکیت نسبت به کار خود داشته باشید.
[H3]
4. اصلاحات و بازبینیها
[/H3]
معمولاً در هر پروژه پایاننامه، نیاز به اصلاحات و بازبینیهای متعدد وجود دارد. موسسه معتبر باید متعهد به انجام این اصلاحات تا رسیدن به رضایت کامل شما و تایید استاد راهنما باشد. اطمینان حاصل کنید که شرایط مربوط به تعداد و نوع بازبینیها در قرارداد اولیه مشخص شده باشد.
[H2]
آینده پژوهش در میکروبیولوژی صنعتی: گرایشها و فرصتها
[/H2]
میکروبیولوژی صنعتی یک رشته پویا است که همواره در حال تحول است. دانشجویان آیندهنگر باید با گرایشهای نوین این حوزه آشنا باشند تا بتوانند موضوعات پژوهشی مرتبط و کاربردی انتخاب کنند. برخی از مهمترین گرایشها عبارتند از:
- **مهندسی متابولیک و سنتتیک بیولوژی:** طراحی و مهندسی میکروارگانیسمها برای تولید کارآمدتر محصولات خاص (مانند بیو-سوختها، داروها و مواد شیمیایی).
- **بیوتکنولوژی محیط زیست:** استفاده از میکروارگانیسمها برای تصفیه فاضلاب، رفع آلودگیهای نفتی، تولید انرژیهای تجدیدپذیر و کاهش ردپای کربن.
- **میکروبیولوژی غذایی نوین:** توسعه پروبیوتیکها، پریبیوتیکها، و کشتهای آغازگر جدید برای بهبود کیفیت و ایمنی مواد غذایی.
- **کشف آنزیمها و متابولیتهای جدید:** جستجو برای میکروارگانیسمهای تولیدکننده آنزیمها یا متابولیتهای ثانویه با کاربردهای صنعتی یا دارویی.
- **توسعه واکسنها و داروهای بیولوژیک:** نقش میکروارگانیسمها در تولید واکسنهای نوترکیب، آنتیبادیها و پروتئینهای درمانی.
- **کاربرد هوش مصنوعی در بهینهسازی فرآیندهای میکروبی:** استفاده از یادگیری ماشین برای پیشبینی رفتار میکروارگانیسمها و بهینهسازی شرایط تخمیر.
این گرایشها فرصتهای پژوهشی فراوانی را برای دانشجویان فراهم میآورند و یک موسسه معتبر میتواند شما را در راستای این مسیرهای نوظهور هدایت کند و از دسترسی به اطلاعات بهروزشده علمی و صنعتی اطمینان حاصل نماید.
[H2]
نتیجهگیری: انتخابی آگاهانه برای آیندهای روشن
[/H2]
انتخاب موسسه مناسب برای نگارش پایاننامه در رشته میکروبیولوژی صنعتی، تصمیمی سرنوشتساز است که میتواند تأثیر عمیقی بر کیفیت پژوهش، موفقیت تحصیلی، و آینده شغلی شما داشته باشد. در این مقاله، ما به بررسی جامع اهمیت این انتخاب، معیارهای کلیدی برای ارزیابی موسسات، معرفی 10 موسسه برتر در این حوزه، و راهکارهای مقابله با چالشهای رایج پرداختیم. همچنین، به نقش فزاینده هوش مصنوعی و گرایشهای نوین پژوهشی در این رشته نیز اشاره کردیم.
به یاد داشته باشید که یک پایاننامه قوی و اصیل، نتیجه ترکیبی از تلاش شخصی شما، راهنماییهای دقیق استاد راهنما، و پشتیبانی متخصصانه یک موسسه معتبر است. با انتخابی آگاهانه و برنامهریزی دقیق، میتوانید مطمئن باشید که نه تنها یک پروژه علمی ارزشمند را به سرانجام میرسانید، بلکه گامی محکم در جهت توسعه دانش و پیشرفت صنعت برمیدارید. برای شروع این مسیر پربار، توصیه میشود با موسسات معرفی شده تماس گرفته و با بررسی دقیق خدمات و رزومه آنها، بهترین گزینه را برای خود انتخاب کنید. با اطمینان در این مسیر قدم بردارید و شاهد شکوفایی تلاشهای علمی خود باشید.
آینده پژوهشی شما همینجاست!
برای دریافت مشاوره تخصصی و گام نهادن در مسیر نگارش یک پایاننامه ممتاز در میکروبیولوژی صنعتی، همین حالا با مشاوران ما در ارتباط باشید.
یا برای کسب اطلاعات بیشتر و ثبت سفارش به وبسایت ما مراجعه کنید:
**پیشنهاد طراحی برای ویرایشگر بلوک:**
این مقاله با ساختاری واکنشگرا (ریسپانسیو) برای نمایش بهینه در موبایل، تبلت، لپتاپ و تلویزیون طراحی شده است. استفاده از پاراگرافهای کوتاه، بولت پوینتها و جداول، خوانایی را در هر سایزی افزایش میدهد.
**رنگبندی پیشنهادی:**
– **پسزمینه اصلی محتوا:** سفید (#FFFFFF)
– **باکسهای اطلاعاتی/CTA:** رنگهای ملایم و دلنشین.
– CTA اولیه: پسزمینه سبز روشن (#E6FFE6)، متن سبز تیره (#1B5E20)، دکمهها سبز متوسط (#4CAF50) و آبی (#2196F3).
– CTA در میانه مقاله: پسزمینه خاکستری روشن (#F8F9FA)، متن آبی تیره (#2C3E50)، دکمهها سبز (#28A745) و آبی روشن (#007BFF).
– باکس خلاصه (اینفوگرافیک): پسزمینه آبی بسیار روشن (#E6F3FF)، حاشیه آبی روشن (#B3D9FF)، متن آبی تیره (#0056B3).
– جدول آموزشی: پسزمینه آبی روشن (#EBF5FB)، سربرگ جدول آبی روشنتر (#CCE5FF)، حاشیه آبی ملایم (#ADD8E6).
– **تیترهای H1:** فونت بزرگ و بولد، رنگ تیره (مثلا #000000 یا #1A202C).
– **تیترهای H2:** فونت کمی کوچکتر و بولد، رنگ تیره مایل به آبی (مثلا #1A5276).
– **تیترهای H3:** فونت معمولیتر و بولد، رنگ آبی متوسط (مثلا #2874A6).
– **متن اصلی:** رنگ خاکستری تیره (#333333) برای خوانایی بهتر.
– **لینکها:** آبی (#007BFF) با تغییر رنگ هنگام هاور (Hover).
**فونت پیشنهادی:** ‘Vazirmatn’, sans-serif برای فارسی و ‘Roboto’, sans-serif برای انگلیسی (در صورت نیاز).
**Schema Markup (JSON-LD) پیشنهادی (برای افزودن به کد سایت):**
“`json
{
“@context”: “https://schema.org”,
“@type”: “Article”,
“headline”: “10 بهترین موسسه انجام پایان نامه رشته میکروبیولوژی صنعتی”,
“image”: [
“URL_به_تصویر_اصلی_مقاله.jpg”
],
“datePublished”: “2023-10-27T09:00:00+08:00”,
“dateModified”: “2023-10-27T10:00:00+08:00”,
“author”: {
“@type”: “Person”,
“name”: “نام نویسنده یا موسسه”
},
“publisher”: {
“@type”: “Organization”,
“name”: “RivanPro”,
“logo”: {
“@type”: “ImageObject”,
“url”: “https://rivanpro.ir/logo.png”
}
},
“description”: “راهنمای جامع برای انتخاب بهترین موسسه انجام پایان نامه در رشته تخصصی میکروبیولوژی صنعتی. شامل معیارها، معرفی موسسات برتر، و راهحل چالشها.”,
“mainEntityOfPage”: {
“@type”: “WebPage”,
“@id”: “https://rivanpro.ir/مقاله-10-موسسه-میکروبیولوژی-صنعتی”
},
“articleSection”: [
“اهمیت انتخاب موسسه مناسب”,
“معیارهای انتخاب موسسه”,
“لیست موسسات برتر”,
“چالشها و راهحلها”,
“نقش هوش مصنوعی”,
“آینده پژوهش”
],
“keywords”: “انجام پایان نامه, میکروبیولوژی صنعتی, بهترین موسسه, مشاوره پایان نامه, نگارش پایان نامه, پایان نامه میکروبیولوژی, استاد پژوهش, ریوان پرو”
}
“`
“`json
{
“@context”: “https://schema.org”,
“@type”: “FAQPage”,
“mainEntity”: [
{
“@type”: “Question”,
“name”: “چگونه بهترین موسسه را برای پایاننامه میکروبیولوژی صنعتی انتخاب کنم؟”,
“acceptedAnswer”: {
“@type”: “Answer”,
“text”: “برای انتخاب بهترین موسسه، به تخصص کادر علمی، سابقه موفقیت، پشتیبانی جامع، تعهد به زمانبندی، رعایت اصول اخلاقی، و هزینههای منطقی توجه کنید.”
}
},
{
“@type”: “Question”,
“name”: “مهمترین چالشها در نگارش پایاننامه میکروبیولوژی صنعتی چیست؟”,
“acceptedAnswer”: {
“@type”: “Answer”,
“text”: “انتخاب موضوع نوآورانه، دسترسی به منابع، انجام آزمایشات پیچیده و تحلیل دادهها، نگارش علمی و آمادگی برای دفاع از جمله مهمترین چالشها هستند.”
}
},
{
“@type”: “Question”,
“name”: “آیا میتوانم از هوش مصنوعی برای نگارش پایاننامهام استفاده کنم؟”,
“acceptedAnswer”: {
“@type”: “Answer”,
“text”: “هوش مصنوعی میتواند به عنوان یک ابزار کمکی در جمعآوری اطلاعات، خلاصهسازی و بررسی اولیه متن مفید باشد، اما هرگز نمیتواند جایگزین تفکر عمیق، تحلیل انتقادی و خلاقیت انسانی شود. همواره باید اصالت و عمق علمی پایاننامه را حفظ کرد.”
}
}
]
}
“`